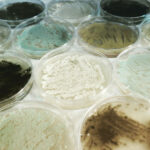

Εργαστήριο Βιοτεχνολογίας
Διευθυντής
Προσωπικό
Το Εργαστήριο Βιοτεχνολογίας (ΦΕΚ, 66Α, 2001) βρίσκεται στη Σχολή Χημικών Μηχανικών (Τομέας IV: Τομέας Σύνθεσης και Ανάπτυξης Βιομηχανικών Διαδικασιών) του Εθνικού Μετσόβιου Πολυτεχνείου (ΕΜΠ).
Το ακαδημαϊκό προσωπικό του εργαστηρίου καλύπτει τις εκπαιδευτικές ανάγκες των μαθημάτων:
- Αρχές Κυτταρικής Βιολογίας και Βιοχημείας (5ου εξ. Χ.Μ)
- Βιοχημική Μηχανική (7ου εξ. Χ.Μ)
- Βιομηχανική Βιοτεχνολογία (8ου εξ. Χ.Μ.)
- Εμβιομηχανική (9ου εξ. Χ.Μ)
- Περιβαλλοντική Βιοτεχνολογία (10ου εξ. Χ.Μ)
Το εργαστήριο υποστηρίζει τα εργαστηριακά μαθήματα:
- Βιομηχανική Βιοτεχνολογία (8ου εξ. Χ.Μ.)
- Εμβιομηχανική (9ου εξ. Χ.Μ)
- Περιβαλλοντική Βιοτεχνολογία (10ου εξ. Χ.Μ)
Οι ερευνητικές δραστηριότητες του Εργαστηρίου αναφέρονται στις παρακάτω περιοχές:
- Βιοτεχνολογική παραγωγή βιοκαυσίμων – Βιοδιυλιστήριο
- Σακχαροποίηση και ζύμωση γεωργικών αποβλήτων για την παραγωγή βιοκαυσίμων δεύτερης γενιάς
- Παραγωγή βιοπολυμερών και βιοδραστικώνενώσεων από υπολειμματική βιομάζα και βιομηχανικά παραπροϊόντα
- Αξιοποίηση λιγνινοκυτταρινούχου βιομάζας για την παραγωγή προϊόντων υψηλής προστιθέμενης αξίας από μικροφύκη
- Χρήση υγρών αποβλήτων ελαιοτριβείου για τη μικροβιακή παραγωγή βιομηχανικών ενζύμων και θρεπτικών φαρμακευτικών προϊόντων
- Βιοκατάλυση
- Ανακάλυψη και παραγωγή νέων ανασυνδυασμένων βιοκαταλυτών για την τροποποίηση του φυτικού κυτταρικού τοιχώματος
- Μελέτη της λειτουργίας / δομής νέων βιοκαταλυτών και μηχανισμού κατάλυσης σε φυσικά υποστρώματα
- Σύνθεση/τροποποίηση βιοδραστικών ενώσεων και πολυμερών βιολογικής προέλευσης
- Τροποποίηση υφασμάτων και υλικών συσκευασίας
- Ενζυμική σύνθεση πρόσθετων τροφίμων (πρεβιοτικά)
- Σύνθεση προϊόντων υψηλής προστιθέμενης αξίας σε μη-συμβατικά συστήματα
- Περιβαλλοντική Βιοτεχνολογία – Βιοεξυγίανση
- Ανακάλυψη νέων θαλάσσιων βιοκαταλυτών για την αποικοδόμηση/απομάκρυνση ρύπων (αλογονομένων, αρωματικών κτλ)
- Σχεδιασμός διεργασιών βιοαποικοδόμησης/απομάκρυνσης ρύπων με ακινητοποιημένα ή ελεύθερα κύτταρα [διαμόρφωση βιοαντιδραστήρων (CSTR, PBR) και μελέτη λειτουργίας αυτών]
- Ανάπτυξη και αξιολόγηση καινοτόμων βιοκαταλυτών και διεργασιών για την αποτελεσματική αποθείωση πετρελαϊκών κλασμάτων
- Βιοπληροφορική – Μεταβολική Μηχανική
- Μεταβολική μηχανική (μεταβολική ανάλυση ροών, ανάλυση μεταβολικού ελέγχου, χρήση δεδομένων ενζυμικών κινητικών σε συστημικό επίπεδο)
- Λειτουργική (μετα)γενωμική και μεταγραφωμική (ερμηνεία πειραμάτων microarrays, ανάλυση δεδομένων αλληλούχισης νέας γενιάς DNA & RNA, ανάλυση υποκινητών)
- Ανάλυση μονοπατιών (αυτοματοποιημένη κατασκευή μεταβολικών και σηματοδοτικών μονοπατιών)
Υποδομές Εργαστηρίου Βιοτεχνολογίας
Το Εργαστήριο Βιοτεχνολογίας καλύπτει μια επιφάνεια περίπου 400 m2 διαθέτοντας την απαραίτητη υποδομή ξεκινώντας από τη μελέτη γονιδιωμάτων και την ετερόλογη έκφραση γονιδίων ενδιαφέροντος, μέχρι την παραγωγή ενός τελικού προϊόντος σε πιλοτική κλίμακα συμπεριλαμβάνοντας τη κατάντη διεργασία απομόνωσης του. Συγκεκριμένα διαθέτει: (α) υπολογιστική δύναμη που περιλαμβάνει τα εξής: i) 2 διακομιστές (servers) o καθένας εκ των οποίων αποτελείται από 64 πυρήνες (CPUs), 512GB RAM, ~7TB χωρητικότητα σκληρού δίσκου και ii) 1 διακομιστή που αποτελείται από 64 πυρήνες (CPUs), 256 GB RAM, ~500 GB χωρητικότητα σκληρού δίσκου, (β) υποδομές μοριακής βιολογίας (PCR, μονάδες ηλεκτροφόρησης και ηλεκτροδιάτρησης, υπέρηχους λύσης κυττάρων), (γ) υποδομές για την καλλιέργεια βακτηρίων, ζυμών, μυκήτων και μικροφυκών μικρής κλίμακας (αναδευόμενοι επωαστήρες, φωτο-επωαστήρες) και (δ) ευρεία υποδομή βιοαντιδραστήρων βυθισμένης καλλιέργειας (βιοαντιδραστήρες όγκου εργασίας από 50 mL έως 150 L), πρωτότυπων φωτοβιοαντιδραστήρων και βιοαντιδραστήρων στερεάς κατάστασης. Επιπλέον, το εργαστήριο περιέχει εκτεταμένες υποδομές κατάντης κατεργασίας (συσκευές υπερδιήθησης όγκου εργασίας από 10 mL έως 100 L, στήλες και υλικά χρωματογραφίας διαχωρισμού πρωτεϊνών όπως ιοντοανταλλαγής, υδρόφοβων αλληλεπιδράσεων, μοριακής διήθησης και συγγένειας) και τέλος αναλυτικές υποδομές αέριας και υγρής χρωματογραφίας (HPLC, GC, HPAEC, GPC) για την ταυτοποίηση και ποσοτικοποίηση μεταβολιτών και ζυμωτικών προϊόντων.